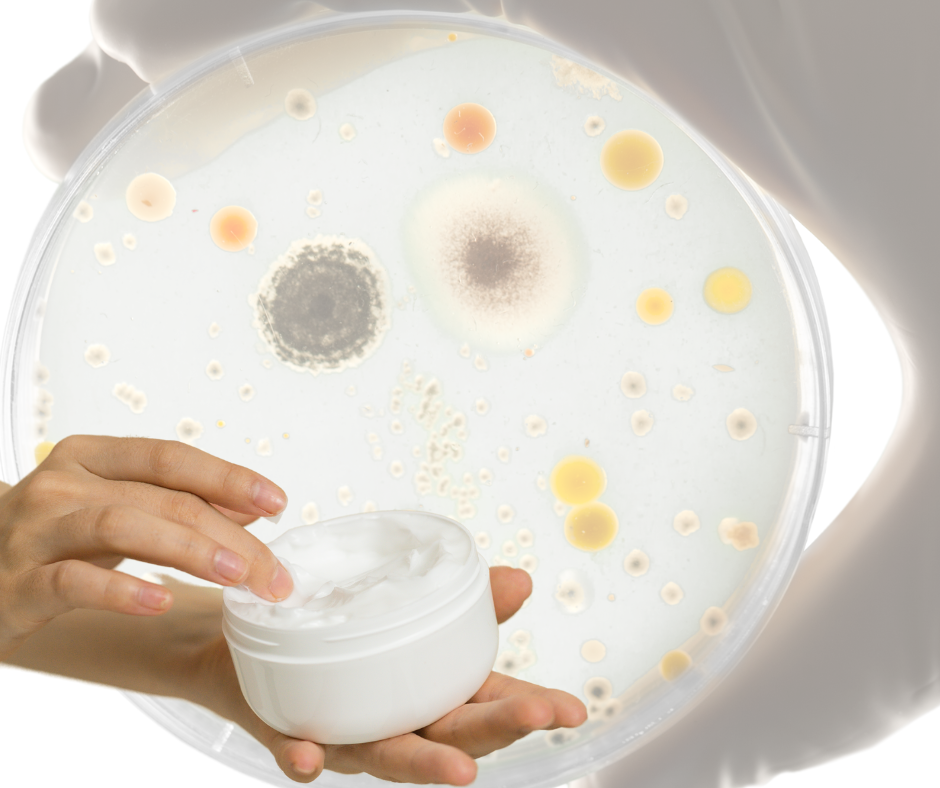
Utilizarea produselor cosmetice în timpul sarcinii. Partea a III-a.

Laboratorul de percepții

Mini-adulți, maxi-riscuri. Ca farmacist, mă uit în primul rând la siguranța ingredientelor. Da, există produse de skincare pentru copii care sunt blânde, testate dermatologic și formulate corect. Ca mamă, mă uit la mesajul pe care îl primește copilul meu, la impactul emoțional și social pe termen lung și mă interesează să știu cum recepționează...
Citeste mai mult

Bronzul perfect sau arsura perfectă? Ori de căte ori vorbim despre vară, ne raportăm la soarele de pe cer, iar imaginația noastră de cele mai multe ori ne poartă imediat pe o plajă. Acolo, sub cerul senin, ne proiectăm pe noi înșine cu un bronz perfect bucurându-ne de câteva zile libere. În realitate însă, acel bronz perfect generat de imaginația noastră,...
Citeste mai mult

În ultimii ani a crescut considerabil interesul pentru stilizarea unghiilor cu produse care rezistă mai mult timp. Practic, au fost dezvoltate oje rezistente care se întăresc și aderă la suprafața unghiei datorită interacțiunii dintre ingrediente și lumina UV. De exemplu, aceste oje pot conține benzofenone (folosite și în produsele de protecție solară), care absorb energia...
Citeste mai mult

Anul 2025 începe cu semne promițătoare, mai ales în domeniul frumuseții, care continuă să fie o reflecție a dorințelor și valorilor societății. Deși în articolele trecute am discutat despre cum trendurile nu ar trebui să ne dicteze alegerile—de la modul în care ne îmbrăcăm până la ceea ce punem pe piele—este greu să ignorăm...
Citeste mai mult

Alte substanțe din produsele cosmetice care gen erează preocupări legate de siguranța utilizării în timpul sarcinii. Retinoizi NU se utilizează în sarcină ! Datorită riscului de expunere cumulativă, Comisia Europeană a limitat foarte mult concentrația de retinoizi în produsele cosmetice, chiar dacă absorbția prin piele a acestora este foarte redusă. Ultima...
Citeste mai mult
De ce sunt utilizați conservanții în produsele cosmetice? Conservanții omoară bacteriile, mucegaiurile și fungii și asigură calitatea microbiologică a produselor cosmetice, în special cele pe bază de apă, protejând produsul de deteriorare și consumatorul de o posibilă infectare. Nu se poate să aplicăm pe piele produse contaminate cu E. coli , sau specii de stafilococi,...
Citeste mai mult

Protecția solară în timpul sarcinii. O preocupare majoră legată de îngrijirea pielii o reprezintă protecția împotriva razelor UV, care sunt corelate in mod direct cu incidența crescută a cazurilor de cancer de piele, dobândit prin expunere la soare. O protecție solară potrivită, ar putea preveni și apariția petelor pigmentare nedorite. Iar filtrele UV au fost introduse în majoritatea produselor cosmetice...
Citeste mai mult

Sunt produsele cosmetice indicate în timpul sarcinii? Desigur! Cu toate că femeia însărcinată devine mult mai atentă la lucrurile cu care intră în contact, nu poate neglija igiena corporală, de exemplu, sau igiena orală, pe care le realizează cu ajutorul unor produse cosmetice, precum: săpunuri, geluri de duș, paste de dinți, ape de gură, creme sau uleiuri de spălare, șampoane, etc. Modul în care această...
Citeste mai mult

Primul pas. Gestionarea secreției de sebum. Sebumul uman este compus din trigliceride (majoritar), esteri de ceară, squalene, acizi grași liberi și cantități mici de colesterol și esteri ai săi. Grăsimile sebumului diferă de cele ale epidermei. Pe lângă termoreglare, sebumul gestionează procese inflamatorii și funcții imunologice, iar anumite lipide ale sale au proprietate antimicrobiană. Pielea trebuie curățată de două...
Citeste mai mult

Acneea reprezintă cea mai frecventă problemă a pielii și vizează mai mult de 85% din populație. Acneea este o afecțiune în care foliculul sebaceu devine blocat de acumularea de celule keratinizate (celule moarte) și exces de sebum, care conduc la apariția comedoanelor deschise (puncte negre) și închise (puncte albe), sau comedoane inflamatorii sub formă de papule/pustule. Uneori, foliculul înfundat și infectat se transformă...
Citeste mai mult

Legislația actuală interzice utilizarea metalelor grele în produsele cosmetice. Comisia Europeană le include în Anexa II a substanțelor interzise. Din păcate, datorită tehnologizării acestei industrii este aproape imposibil să nu fie identificate urme de metale grele în produsele cosmetice, sub formă de impurități. Poluarea, de asemenea, joacă un rol important în contaminarea...
Citeste mai mult

Legătura dintre frumusețe și stima de sine Realizarea și dezvoltarea produselor cosmetice este o provocare ținând cont că preferințele consumatorilor sunt mereu în schimbare, iar listele cu ingrediente permise sunt frecvent revizuite și modificate. Pentru un formulator de produse cosmetice poate fi o adevărată artă realizarea unor formule noi, iar satisfacția este și mai mare atunci când produsul creat își îndeplinește...
Citeste mai mult

Reacții și răspunsuri individuale. Atât în experiența profesională cât și în viața personală am întâlnit des situații în care un produs dermatocosmetic sau cosmetic achiziționat la recomandarea specialistului, sau în baza recenziilor pozitive ale cunoscuților sau necunoscuților, să nu se ridice la nivelul așteptărilor, sau să genereze anumite reacții nedorite. Desigur, aceasta din urmă...
Citeste mai mult

Reglementări legislative. Pe măsură ce îngrijorările privind siguranța produselor cosmetice a crescut de-a lungul anilor, a fost necesară implementarea unor reguli pentru a proteja consumatorul. În SUA, prima lege federală privind stabilirea standardelor de siguranță și puritate a produselor cosmetice, a fost adoptată de FDA în 1938, iar Fair Packaging and Labeling Act (FPLA) a fost pus în aplicare în 1966....
Citeste mai mult

De-a lungul secolelor, utilizarea produselor cosmetice și de îngrijire personală a suferit diverse procese de adaptare. Spre exemplu în Evul Mediu, utilizarea machiajului și a parfumului a fost descurajată de Biserică, deoarece aceste produse erau adesea asociate cu vanitatea, iar Biserica Catolică susținea că vanitatea este o formă de mândrie, unul dintre cele șapte păcate. Cu toate...
Citeste mai mult

Elisabeta I, ulei pe panou atribuit lui George Gower, în jurul anului 1588. Britannica.com Fie că doreau să intimideze sau să impresioneze alte persoane, fie că le utilizau în diverse ceremonii spirituale, ori pentru a corecta diferite defecte, sau pur și simplu pentru a-și menține tinerețea, preparatorii din toate timpurile au utilizat o mare varietate de ingrediente în formulele lor cosmetice....
Citeste mai mult

Nevoia de dezvoltare a produselor cosmetice. Dintotdeauna a existat un interes deosebit pentru produsele de îngrijire a pielii și de machiaj. În funcție de relief, cultură și materia primă de care au dispus, oamenii au creat încă din cele mai vechi timpuri o varietate de preparate cu ajutorul cărora au reușit să protejeze pielea de factorii agresivi ai mediului extern. În egală măsură, au creat și preparate de îngrijire...
Citeste mai mult
Suport clienti
laborator@hatix.ro